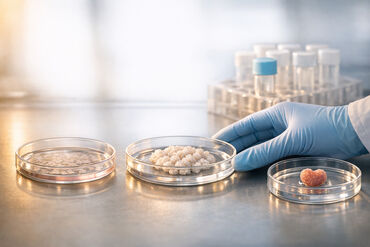
69a8891c12de151ab0272981 1772709529138

iPSC Clinical Trials: The Latest Breakthroughs in Stem Cell Research
The field of iPSC (induced pluripotent stem cell) research is transforming medicine. By reprogramming adult cells into versatile stem cells, scientists are developing therapies for conditions like Parkinson’s, macular degeneration, spinal cord injuries, and even fertility challenges. These treatments are tailored to patients, reducing immune rejection risks and advancing personalized medicine.
Key highlights:
- Parkinson’s Disease: Trials show improved motor function with iPSC-derived dopamine-producing cells.
- Eye Diseases: Retinal cell patches are being tested to treat macular degeneration.
- Spinal Cord Injuries: Early studies demonstrate motor recovery using hematopoietic and mesenchymal stem cells.
- Fertility: iPSC-based ovarian support cells are cutting IVF treatment times.
Despite progress, challenges like tumor risks, immune rejection, and manufacturing complexity remain. Advances in newborn stem cell banking, like Americord’s CryoMaxx™ technology, are ensuring long-term cell viability for future iPSC applications. With over 115 global trials and growing, iPSC therapies are reshaping regenerative medicine.
The Current State of iPSC Clinical Trials
iPSC Trials in 2026: A Global Overview
As of early 2026, researchers around the world are conducting trials targeting a variety of diseases.
Parkinson's disease continues to lead iPSC research efforts. Kyoto University Hospital recently wrapped up a Phase I/II trial (jRCT2090220384) led by Professor Jun Takahashi. In this study, seven patients received bilateral transplants of iPSC-derived dopaminergic progenitors. Results at 24 months showed that 4 out of 6 patients experienced significant motor improvements, with PET scans confirming that transplanted cells were producing dopamine. The high-dose group saw a 63.5% increase in dopamine synthesis, compared to just 7.0% in the low-dose group. Meanwhile, the University of California, San Diego initiated its own Phase I/II trial (NCT06482268) in June 2024. This trial is evaluating CT1-DAP001 in seven participants aged 40–75, with a four-year follow-up period.
Progress is also being made in eye diseases. The National Eye Institute is conducting a Phase I/IIa trial (NCT04339764) for Geographic Atrophy, a severe form of dry age-related macular degeneration. This study involves transplanting a 2x4 mm autologous iPSC-derived retinal pigment epithelium patch grown on a biodegradable scaffold. It plans to enroll 12 participants, monitoring them over five years to evaluate safety and patch durability.
Efforts to address spinal cord injuries are underway at Keio University, where researchers are using iPSC-derived neural stem and progenitor cells to treat subacute injuries. In the field of heart failure, Heartseed Inc., in collaboration with Novo Nordisk, is advancing HS-001, a therapy utilizing purified iPSC-derived ventricular cardiomyocytes, in Phase I/II trials.
In oncology, iPSC-derived immune cells are showing promise. Companies like Fate Therapeutics and Century Therapeutics are developing Natural Killer (NK) and T-cell therapies to combat B-cell lymphoma and solid tumors. By early 2026, over 12 companies are working on more than 15 pipeline drugs in this area. Century Therapeutics is also testing CNTY-101 in its CARAMEL Phase I/II trial for B-cell-mediated autoimmune diseases.
Beyond these areas, researchers are exploring iPSC applications in diabetes (using pancreatic islet cells) and fertility. In January 2025, Gameto achieved FDA clearance for Fertilo, the first iPSC-based therapy to enter a U.S. Phase 3 trial. This treatment uses iPSC-derived ovarian support cells to mature eggs outside the body, cutting hormone injections by 80% and reducing IVF cycles from 10–14 days to just 2–3 days.
While these advancements are exciting, several challenges still need to be addressed.
Key Challenges Facing iPSC Clinical Trials
Despite the progress, some obstacles continue to hinder the transition from research to widespread clinical use. One of the biggest concerns is tumorigenicity - the risk that undifferentiated iPSCs could form tumors after transplantation. To mitigate this, researchers are employing advanced cell-sorting techniques to remove any undifferentiated cells before use.
Another hurdle is immune rejection, particularly for allogeneic (donor-derived) therapies. These "off-the-shelf" treatments are quicker and cheaper to produce than autologous (patient-specific) therapies, but they often require patients to take immunosuppressive drugs like tacrolimus.
Manufacturing and scalability also pose challenges. Producing clinical-grade iPSCs at scale while maintaining genetic stability and meeting regulatory standards from agencies like the FDA, EMA, and PMDA is a complex process. To address this, companies are developing integrated workflows that include gene editing and Master Cell Bank manufacturing, aiming to streamline production and speed up Investigational New Drug (IND) submissions.
In Parkinson's disease trials, graft-induced dyskinesia (GID) - involuntary movements caused by contamination with non-target cells like serotonergic neurons - has emerged as a concern. Researchers are refining their methods to ensure that only the desired dopaminergic neurons are included in the final product.
Despite these hurdles, the safety data for iPSC therapies remains encouraging. For instance, in the Kyoto Parkinson's trial, 72 out of 73 reported adverse events were mild, with none classified as serious or life-threatening.
Major iPSC Trials by Disease Category
iPSC Trials for Age-Related Macular Degeneration
Several studies highlight how iPSC therapy is being used to tackle challenges in ophthalmology. One notable example comes from the RIKEN Institute in Japan, which conducted the first autologous transplantation of iPSC-derived retinal pigment epithelium (RPE) sheets for a patient with neovascular AMD. Under the leadership of Dr. Masayo Mandai, the procedure showed that the RPE sheets could integrate without causing immune rejection or tumor formation. However, it did not lead to significant vision improvement for the patient.
Another key trial, initiated by Sumitomo Pharma and HEALIOS K.K. in August 2024, focuses on HLCR011, an allogeneic iPSC-derived RPE cell suspension aimed at treating RPE tears. Conducted at Kyushu University Hospital and led by Professor Koh-Hei Sonoda, this Phase I/II trial is a multicenter, randomized, double-blind study involving 20 participants. By using HLA-matched donor cells, the trial seeks to minimize the risk of immune rejection.
The National Eye Institute (NEI) is also exploring a patch-based approach for Geographic Atrophy through its trial (NCT04339764). This method offers an alternative to cell suspension therapies.
"The iRPE patch in this study is manufactured from stem cells made from an individual's own blood cells, which offers the potential of a personalized therapy and may decrease the chance that the body would reject the cells." – National Eye Institute (NEI)
Research using human embryonic stem cell-derived RPE patches has already shown promising results, with visual acuity improvements of 21 to 29 ETDRS letters. The transition from autologous therapies to allogeneic "off-the-shelf" solutions is expected to make treatments more accessible, speeding up the delivery of these therapies and broadening their impact.
iPSC Trials for Parkinson's Disease
Parkinson's disease research is leveraging iPSC therapies to replace dopamine-producing neurons lost due to the condition. Both autologous (patient-specific) and allogeneic (ready-made) approaches are being explored. Autologous methods reduce the need for immunosuppression, while allogeneic options offer faster availability. A major challenge in these trials is ensuring the purity of transplanted cells to avoid unwanted effects, such as graft-induced dyskinesia caused by the presence of non-target cells like serotonergic neurons. Researchers are fine-tuning protocols to include only dopaminergic neurons, which are critical for addressing motor symptoms in Parkinson's patients.
iPSC Trials for Spinal Cord Injuries
In December 2021, Keio University researchers achieved a major milestone by transplanting human iPSC-derived neural stem/progenitor cells (iPSC-NS/PCs) into patients with subacute spinal cord injuries. Led by Professor Hideyuki Okano, the study involved four patients who received 2 million cells each within 14 to 28 days after their injuries. By March 2025, results showed no serious adverse events, and half of the participants experienced motor function improvements. One elderly patient even regained the ability to stand unsupported and began walking practice.
"By completing our first transplantation, I believe we've gone from zero to one. There is no time to waste. We can finally pick up the pace in bringing this procedure from the bench to the bedside." – Hideyuki Okano, Professor, Keio University
The Keio team emphasized that cell transplantation is only part of the recovery process. Intensive neurorehabilitation plays a vital role in maximizing outcomes. The transplanted cells are designed to differentiate into neurons and glial cells, helping to rebuild damaged neural circuits and release neurotrophic factors that limit secondary damage. With around 150,000 people in Japan living with spinal cord injuries and 5,000 new cases each year, these advancements have the potential to make a major difference. This progress also opens doors for combining iPSC therapies with long-term stem cell storage strategies to enhance treatment options further.
How iPSC Research Connects to Newborn Stem Cell Banking
Using Cord Blood and Tissue for iPSC Development
The link between iPSC research and newborn stem cell banking is becoming increasingly clear. Both hematopoietic stem cells (HSCs) from cord blood and mesenchymal stem cells (MSCs) from cord tissue can be reprogrammed into iPSCs using advanced techniques. This process provides families with a renewable source of cells that can be transformed into virtually any cell type.
What makes newborn stem cells so ideal for iPSC development? Their pristine condition. These cells are collected at birth, untouched by the effects of aging, illness, or environmental damage. When researchers use non-integrative reprogramming methods, they can create iPSCs with powerful pluripotent capabilities - without altering the genome.
"The stem cells our clients have stored are particularly unique as a starting material as they are collected at birth and offer exceptional value for long-term preservation and future therapeutic applications." – Geoffrey Crouse, President and CEO, CBR
A study published in npj Regenerative Medicine highlighted the potential of cord tissue-derived iPSCs (CT-iMSCs) in treating severe burns. Researchers used these cells with Integra® Dermal Regeneration Templates in a porcine model, achieving faster wound healing and better skin restoration compared to standard approaches. Additionally, iPSC-derived MSCs have shown the ability to generate up to 1,000 times more cells through cumulative passaging than MSCs taken from adult tissues. This scalability underscores the importance of advanced preservation methods, such as Americord's CryoMaxx™ Technology.
Americord's CryoMaxx™ Processing Technology
High-quality stem cells require cutting-edge processing technology, and Americord's CryoMaxx™ Processing Technology delivers just that. This proprietary system ensures maximum cell recovery and viability during collection, processing, and cryopreservation. Samples are stored in 5-compartment vials, allowing families to use portions of the sample at different times without risking the entire supply.
CryoMaxx™ ensures that both cord blood HSCs and cord tissue MSCs remain viable for decades in cryogenic storage. This is crucial because families banking stem cells today may not need them for iPSC reprogramming until years or even decades later, as regenerative medicine therapies continue to evolve. With iPSC-based treatments, like Gameto's Fertilo trial (which received FDA clearance in January 2025), now advancing into Phase 3 clinical trials, the timeline for these therapies is moving faster than anticipated. Properly processed and preserved cells will play a key role in bridging the gap between today's storage and tomorrow's medical breakthroughs.
Conclusion
iPSC clinical trials have made the leap from research labs to practical medical applications. With Phase 3 trials now underway, treatments like Fertilo for fertility and in-utero surgeries using stem cell patches to address spina bifida are becoming accessible. In March 2026, FDA-compliant GMP Master Cell Banks standardized the conversion of stored cells into clinical-grade treatments, speeding up the transition from cell preservation to therapy. These advancements offer real hope to expecting parents.
Newborn stem cells - collected from cord blood, tissue, and placenta - are an ideal foundation for iPSC development. These cells are gathered at birth in pristine condition, untouched by aging or disease, and can be reprogrammed into nearly any cell type. This high quality is essential for successful therapies. The CuRE trial at UC Davis Health demonstrated that placenta-derived stem cells could safely repair birth defects before birth, with all six treated infants showing reversed hindbrain herniation and no negative side effects.
Banking stem cells today keeps future treatment possibilities open for conditions like Parkinson's disease (which affects over 1 million Americans), age-related macular degeneration, and fertility challenges. iPSC-derived therapies have already reduced the need for hormone injections by 80% in fertility treatments and achieved 94% survival rates in blood disorder transplants using expanded cord blood. The quality of stored cells plays a critical role in making these advances possible.
Americord’s CryoMaxx™ Processing Technology ensures long-term cell viability, while 5-compartment vials allow selective access to parts of the sample without compromising the rest. This feature is invaluable as new treatment opportunities may arise throughout a child’s life.
With regenerative medicine progressing rapidly, banking newborn stem cells today positions families to take advantage of tomorrow’s cutting-edge treatments.
FAQs
Are iPSC treatments available now in the U.S.?
Yes, iPSC treatments are accessible in the U.S., primarily through ongoing clinical trials. These include the FDA-approved Phase 3 trial for Fertilo by Gameto, as well as early-stage studies targeting conditions such as Parkinson's disease and retinal disorders. As of March 2026, these trials mark important advancements in the fields of regenerative medicine and stem cell research.
How do iPSC therapies reduce immune rejection?
iPSC therapies aim to lower immune rejection risks by creating cell lines that better align with the recipient's immune system. For instance, iPSC lines are developed with specific HLA haplotypes commonly found in the U.S., making them a closer match for a larger number of recipients. Additionally, breakthroughs in genetic engineering and production processes have led to "off-the-shelf" options. These products are designed to minimize immune reactions, which in turn reduces the reliance on immunosuppressive drugs.
Why bank cord blood or tissue for future iPSC use?
Banking cord blood or tissue allows for the preservation of stem cells, which can later be transformed into induced pluripotent stem cells (iPSCs). These iPSCs are incredibly flexible, with the potential to develop into many different types of tissues. This stored resource could pave the way for personalized medical treatments, such as repairing damaged tissues, tackling genetic disorders, or even aiding in fertility treatments. As regenerative medicine continues to progress, these preserved cells might play a key role in developing therapies for conditions like spina bifida or other congenital disabilities.
The views, statements, and pricing expressed are deemed reliable as of the published date. Articles may not reflect current pricing, offerings, or recent innovations.